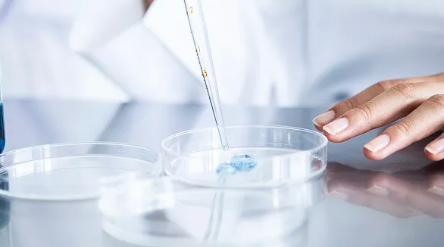
image.png

中華干細(xì)胞國(guó)際研究中心怎么樣,本文詳細(xì)介紹
2024-09-09 14:02:57 來源: 小編 咨詢醫(yī)生
本文將詳細(xì)探討中華干細(xì)胞國(guó)際研究中心的研究背景、研究方向、技術(shù)優(yōu)勢(shì)以及行業(yè)影響力,以幫助讀者更好地了解這一重要的科研機(jī)構(gòu)。
一、中華干細(xì)胞國(guó)際研究中心概述
中華干細(xì)胞國(guó)際研究中心(China International Stem Cell Research Center,CISCRC)成立于近年來,旨在推動(dòng)干細(xì)胞研究與應(yīng)用的國(guó)際化進(jìn)程。中心依托多家國(guó)內(nèi)外頂尖高校和科研機(jī)構(gòu),匯集了一批在干細(xì)胞領(lǐng)域具備深厚背景的科研團(tuán)隊(duì)。
二、研究方向與重點(diǎn)領(lǐng)域
中華干細(xì)胞國(guó)際研究中心的研究方向主要集中在以下幾方面:
1.基礎(chǔ)研究:聚焦干細(xì)胞生物學(xué)的基礎(chǔ)研究,旨在揭示干細(xì)胞的分化機(jī)制、增殖能力以及細(xì)胞命運(yùn)決定的分子機(jī)制。這些研究為干細(xì)胞的臨床應(yīng)用提供了理論支撐。
2.再生醫(yī)學(xué):通過干細(xì)胞技術(shù)開發(fā)新型的再生醫(yī)學(xué)治療方案,尤其是在神經(jīng)系統(tǒng)疾病、心血管疾病和糖尿病等領(lǐng)域,探索可行的干細(xì)胞移植和治療方法。
3.疾病模型:利用干細(xì)胞構(gòu)建人類疾病模型,以深入理解各種疾病的發(fā)病機(jī)制,并為藥物篩選和療法研發(fā)奠定基礎(chǔ)。
4.臨床轉(zhuǎn)化:研究中心同時(shí)致力于將基礎(chǔ)研究轉(zhuǎn)化為臨床應(yīng)用,推動(dòng)干細(xì)胞在臨床治療中的實(shí)際應(yīng)用,提升治療效果。
三、技術(shù)優(yōu)勢(shì)
中華干細(xì)胞國(guó)際研究中心在多項(xiàng)技術(shù)上具備領(lǐng)先優(yōu)勢(shì),比如:
1.自體干細(xì)胞技術(shù):研發(fā)了一系列自體干細(xì)胞提取和培養(yǎng)技術(shù),確保治療過程的安全性和有效性。
2.基因編輯技術(shù):運(yùn)用CRISPR等基因編輯技術(shù),對(duì)干細(xì)胞進(jìn)行精準(zhǔn)修改,以解決遺傳性疾病和提高干細(xì)胞的治療效果。
3.大規(guī)模細(xì)胞培養(yǎng)技術(shù):中心掌握了現(xiàn)**物反應(yīng)器技術(shù),能夠?qū)崿F(xiàn)干細(xì)胞的高效、大規(guī)模培養(yǎng),為臨床應(yīng)用提供充足的細(xì)胞來源。
四、行業(yè)影響力與前景
中華干細(xì)胞國(guó)際研究中心不僅在科技創(chuàng)新方面處于領(lǐng)先地位,還通過國(guó)際合作與交流,積極參與全球干細(xì)胞研究領(lǐng)域的合作項(xiàng)目。其多項(xiàng)研究成果已在國(guó)際權(quán)威期刊上發(fā)表,提升了中國(guó)在全球干細(xì)胞領(lǐng)域的影響力。
作為未來醫(yī)學(xué)的重要組成部分,干細(xì)胞技術(shù)的發(fā)展前景無疑是巨大的。中華干細(xì)胞國(guó)際研究中心通過與全球科學(xué)家和行業(yè)領(lǐng)軍者的互動(dòng),力求在未來實(shí)現(xiàn)更多的創(chuàng)新突破,為患者提供更多的治療選擇。
總結(jié)
整體來看,中華干細(xì)胞國(guó)際研究中心在干細(xì)胞研究及其應(yīng)用方面取得了顯著成就。其專業(yè)的研究團(tuán)隊(duì)、前沿的技術(shù)及廣泛的國(guó)際合作,為推動(dòng)干細(xì)胞技術(shù)的發(fā)展,推動(dòng)再生醫(yī)學(xué)的落地奠定了堅(jiān)實(shí)基礎(chǔ)。
未來,隨著干細(xì)胞研究的不斷深入及其應(yīng)用的日益廣泛,中華干細(xì)胞國(guó)際研究中心必將為更多的患者帶來希望,并推動(dòng)全球醫(yī)學(xué)科技的發(fā)展。希望以上介紹能夠幫助讀者更深入地了解中華干細(xì)胞國(guó)際研究中心,以及其在干細(xì)胞研究領(lǐng)域的重要作用與影響。
- 2024-11-07江西干細(xì)胞捐贈(zèng)機(jī)構(gòu)有哪些,如何選擇正規(guī)干細(xì)胞捐贈(zèng)機(jī)構(gòu)
- 2024-09-04威海干細(xì)胞存儲(chǔ)的機(jī)構(gòu)有幾家
- 2024-10-11湖北牙髓干細(xì)胞有哪些作用?應(yīng)用范圍如何?
- 2024-10-12深圳哪家干細(xì)胞機(jī)構(gòu)服務(wù)好?有什么評(píng)價(jià)標(biāo)準(zhǔn)?
- 2024-11-23廣州哪里能打干細(xì)胞,干細(xì)胞治療安全有效嗎
- 2024-11-07301醫(yī)院干細(xì)胞治療成功率如何?如何選擇最佳干細(xì)胞治療醫(yī)院?
- 2024-09-19干細(xì)胞瘦小腿效果好嗎多少錢一針
- 2024-09-13干細(xì)胞異體注射抗衰老的原理與作用
- 2024-10-11干細(xì)胞治療費(fèi)用多少?如何選擇性價(jià)比高的治療機(jī)構(gòu)?
- 2024-10-11江蘇干細(xì)胞培養(yǎng)費(fèi)用如何??jī)r(jià)格與效果成正比嗎?
- 2024-09-26帕金森病干細(xì)胞治療效果如何,與現(xiàn)有治療相比優(yōu)勢(shì)在哪
- 2024-09-23干細(xì)胞較好的專業(yè)機(jī)構(gòu)排名,這十家口碑良好
- 2024-09-10干細(xì)胞技術(shù)應(yīng)用到眼角膜移植時(shí),優(yōu)勢(shì)在哪里
- 2024-10-10干細(xì)胞治療鼻炎真的有效果嗎?看看專家解讀
- 2024-08-30造血干細(xì)胞移植手術(shù)大概多少錢
- 2024-09-03間充質(zhì)干細(xì)胞移植醫(yī)院,哪家醫(yī)院有間充質(zhì)干細(xì)胞
- 2024-09-19皮膚干細(xì)胞修復(fù)技術(shù),干細(xì)胞修復(fù)皮膚的作用
- 2024-07-31干細(xì)胞治療的副作用,干細(xì)胞治療的費(fèi)用高嗎
